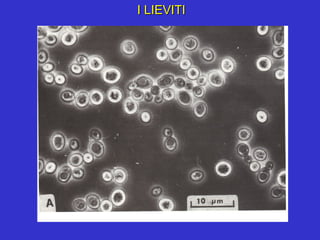
I LIEVITI

I miceti sono organismi eucarioti eterotrofi che possono essere unicellulari o pluricellulari e sono caratterizzati da una parete cellulare di chitina. Svolgono ruoli ecologici nella degradazione del materiale organico e nella produzione di metaboliti utili in campo medico e biotecnologico. Le micosi possono essere superficiali, sottocutanee o sistemiche, e la loro patogenesi dipende da fattori ambientali e condizioni immunologiche dell'ospite.